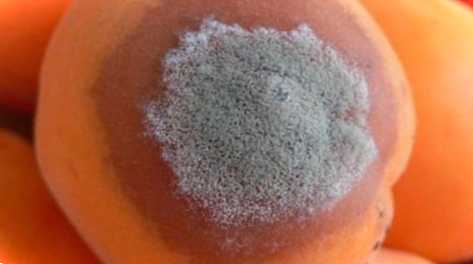

Поширені хвороби абрикосових дерев та їх ефективне лікування


Не кожен садівник має абрикосове дерево у своєму ландшафті, але якщо воно у вас є, то ви, ймовірно, доклали чимало зусиль, щоб знайти його і посадити в потрібному місці. Але чи знаєте ви, як визначити хвороби абрикосового дерева? Продовжуйте читати, щоб дізнатися про лікування проблем у абрикосів, включаючи бактеріальну виразку, відмирання, фітофтору, гниль стиглих плодів та дірчасту плямистість.
Хвороби абрикосових дерев та їх лікування
Існує багато видів хвороб абрикосів, хоча майже всі їх викликаються звичайними підозрюваними - бактеріями чи грибками. У більшості випадків без застосування хімічних препаратів не обійтися, дерево буде в будь-якому разі слабким і, швидше за все, один врожай буде втрачено.
Бактеріальна виразка
Серед найбільш неприємних проблем з абрикосами бактеріальна виразка викликає утворення темних, запалих виразок у основи нирок і безладно вздовж стовбурів та кінцівок. Камедь може сочитися через ці рани, коли дерево виходить зі сплячки навесні, або дерево може раптово померти.
Як тільки дерево заражене бактеріальною виразкою, ви дуже мало можете йому допомогти, хоча деякі виробники досягли обмеженого успіху при застосуванні високих доз міді фунгіциду при опаданні листя.
Повернення Еутіпи
Набагато рідше, ніж бактеріальна виразка, відмирання еутипи, також відоме як гуммоз або відмирання кінцівок, викликає раптове в'янення абрикосів пізньої весни чи літа. Кора знебарвлена і мокра, але, на відміну від бактеріальної виразки, листя залишається прикріпленим до хворих або мертвих гілок.
Відмираюча гілка може бути зрізана з дерев після збирання врожаю. Обов'язково видаліть принаймні 30 см здорової тканини разом із хворою гілкою та обробіть рани від обрізання фунгіцидом загального призначення.
Фітофтора

Фітофтора зустрічається в основному в садах, де поганий дренаж або рослини хронічно перезволожені. Коріння та крони пошкоджені різною мірою, але серйозно пошкоджені абрикосові дерева можуть зруйнуватися невдовзі після першого періоду теплої погоди в році. Хронічні інфекції призводять до зниження бадьорості та раннього обпадання листя, а також до загальної слабкості дерева.
Якщо ваше дерево переживе перший весняний приплив фітофтори, обприскайте листя фосфорною кислотою або мефеноксамом і усуньте проблему з дренажем, але знайте, що може бути пізно рятувати ваш абрикос.
Гнилия стиглих плодів
Також відома просто як бура гнилизна, гниль стиглих плодів є однією з найбільш неприємних хвороб абрикосових дерев. У міру дозрівання плодів на них утворюється невелика коричнева, просочена водою поразка, яка швидко поширюється, руйнуючи весь плід. Незабаром на поверхні плода з'являються коричнево-сірі суперечки, що поширюють хворобу. Гнило стиглих плодів також може виявлятися у вигляді цвітіння, ураження гілок або виразок на гілках, але найбільш поширена форма гниття плодів.
Як тільки стигла плодова гнилизна захопить владу, ви нічого не зможете зробити для цього врожаю, крім як, видалити заражені фрукти. Очистіть все сміття, що впало, і видаліть всі фрукти, які залишилися на дереві і навколо нього в кінці сезону, потім почніть попередню обробку вашого дерева за розкладом, починаючи з весни. Фунгіциди, такі як фентиконазол, піраклостробін або фенгексамід, часто використовуються для захисту фруктів від гнилі стиглих плодів.
Дірчаста плямистість
Абрикоси з маленькими круглими фіолетовими плямами на листі можуть бути заражені хворобою дробових отворів. Плями іноді висихають, але заражене листя рідко відмирає або падає з дерева. Плями також можуть з'явитися на плодах перед тим, як покритися струпами - якщо ці струпи відпадуть, залишаться нерівні ділянки.
Одноразового застосування фунгіциду під час спокою може бути достатньо, щоб захистити абрикоси від хвороби дробових отворів. Бордоську суміш або спрей з фіксованою міддю можна наносити на сплячі дерева або використовувати зірам, хлороталоніл або азоксистробін на квітучих або плодоносних деревах, на яких видно ознаки захворювання дірчастою плямистістю.

